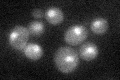
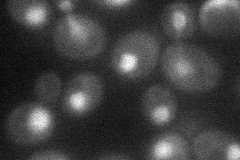
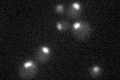

View description
Component of U1 snRNP required for mRNA splicing via spliceosome; may interact with poly(A) polymerase to regulate polyadenylation; homolog of human U1 70K protein
Localization:
Intensity:
Fold change:
Significance:
-
C’ GFP library in SD
nucleus24.63 -
N' NOP1pr-GFP in SD
nucleus38.5557 -
N' TEF2pr-mCherry in SD

missing0 -
N' NATIVEpr-GFP in SD

missing0 -
N' TEF2pr-VC and Cyto-VN in SD

below threshold26.66 -
C’ GFP library in SD+DTT

nucleus21.050.85No -
C’ GFP library in SD+H2O2

nucleus19.530.79No -
C’ GFP library in Starvation Media
nucleus24.280.98No -
C’ GFP library on the background of Pup2-DaMP

nucleus -
C’ GFP library on the background of CCT mutant

nucleus23.75370.964087No
